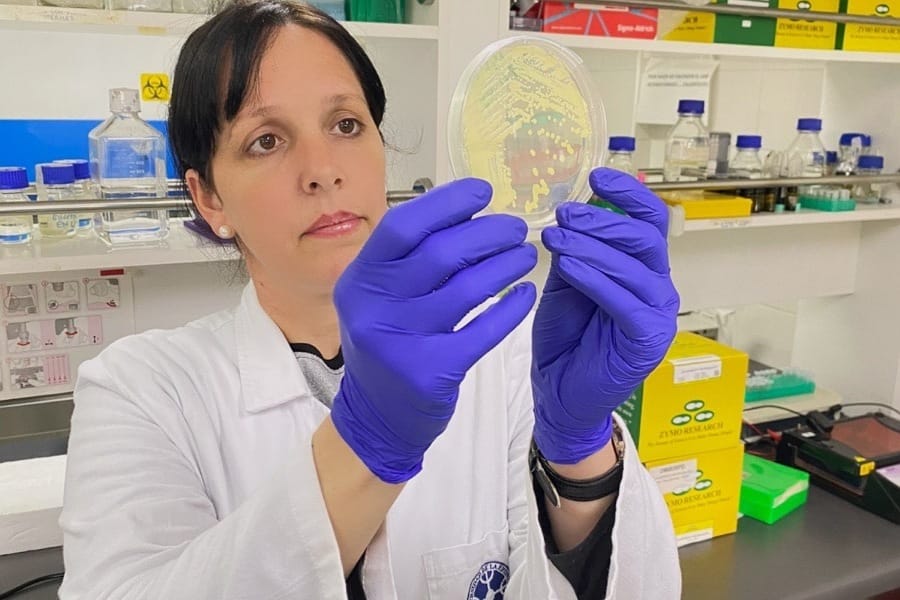

|
La propuesta para envasados industriales ofrece un método más sustentable y eficaz para preservar productos cárnicos, mediante características innovadoras que evitan la proliferación de microorganismos. Se trata de una fibra electrohilada cargada de compuestos bioactivos de la Antártica.
|
Dayaimi González Reyes, estudiante del Doctorado en Ciencias mención Biología Celular y Molecular Aplicada fue seleccionada como ganadora de “Sinergia I+D: Doctorados UFRO – Agrosuper”, convocatoria impulsada por la empresa Agrosuper y la Dirección de Innovación y Transferencia Tecnológica de la Universidad de La Frontera. Esta alianza colaborativa se da en el marco de las acciones estratégicas del InES de Innovación UFRO y toma fuerza en la articulación con el sector público y privado para generar soluciones innovadoras que aborden -en este caso- desafíos dentro de la cadena de valor de Agrosuper, promoviendo la investigación aplicada y fortaleciendo la capacidad de conexión de la academia. I+D DE COMPUESTOS DE LA ANTÁRTICA La propuesta de Dayaimi González surge de la investigación realizada a nivel de tesis doctoral y plantea el desarrollo de una fibra elaborada de compuestos antárticos activos y polímeros biodegradables que ha sido aplicada al envasado de carne y productos cárnicos. La tecnología ofrece un gran potencial para la conservación, debido a las características antimicrobianas y antioxidantes. “Al momento ya está demostrada la actividad antioxidante y antimicrobiana de la cepa”, señala Dayaimi González y explica que en el proceso de desarrollo actual se encuentra la elaboración de la fibra electrohilada. “La solución que hemos propuesto a Agrosuper tiene diferentes ventajas, por una parte, responde a la innovación en el uso de bacterias antárticas aplicadas a procesos alimentarios y, por otro, destaca su doble funcionalidad”. La adjudicación de esta convocatoria para la estudiante de postgrado, no solo pone en valor la calidad y relevancia de la investigación realizada en el Doctorado en Ciencias mención Biología Celular y Molecular Aplicada, sino que también refuerza la importancia de generar vínculos estratégicos entre la academia y la industria, que permitan entrar a procesos que involucran un gran volumen. La directora de Innovación y Transferencia Tecnológica UFRO, Dra. Paola Durán así lo reitera. “Sabemos que existe una serie de problemáticas a las cuáles responder con el conocimiento generado desde la academia que se va construyendo y articulando por medio del vínculo entre ciencias aplicadas y la innovación como respuesta a desafíos concretos”. Por su parte, el gerente de Innovación de Agrosuper, Cristián Meyer, mencionó que se ha cumplido el objetivo. “El propósito de esta iniciativa ha sido entusiasmar a las y los estudiantes de doctorado respecto de las líneas de producción que tenemos en pollos, cerdos y pavos, con la mirada puesta en el desarrollo y mejoramiento de los procesos con tecnología”. El director académico de postgrado y director del Doctorado BIOMOL, Dr. Luis Salazar, expresó su satisfacción y orgullo por el logro de Dayaimi González. “Este proyecto es un testimonio del talento y la dedicación de nuestros estudiantes de doctorado. La investigación de Dayaimi no solo destaca por su innovación, sino también por su relevancia práctica en la industria alimentaria. Estamos seguros de que su trabajo tendrá un impacto significativo en la preservación de alimentos y abrirá nuevas puertas para futuras colaboraciones entre la academia y la industria”. Un “match” que se ha dado a cabalidad en esta investigación doctoral que es dirigida por la Dra. Francisca Acevedo desde el Doctorado de BIOMOL y esta alianza con Agrosuper fortalecida a través de InES de Innovación y la dirección de Innovación y Transferencia Tecnológica de la Vicerrectoría de Investigación y Postgrado. Fuente: Dirección de Innovación y Transferencia Tecnológica |